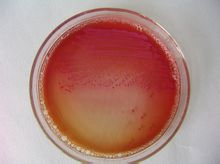
大腸桿菌平板培養基

主要特點
大腸桿菌是人和許多動物腸道中最主要且數量最多的一種細菌,周身鞭毛,能運動,無芽孢。主要生活在大腸內。
 大腸桿菌
大腸桿菌 1、大腸桿菌是細菌,屬於原核生物;具有由肽聚糖組成的細胞壁,只含有核糖體簡單的細胞器,沒有細胞核有擬核;細胞質中的質粒常用作基因工程中的運載體。
2.大腸桿菌的代謝類型是異養兼性厭氧型。
3.人體與大腸桿菌的關係:在不致病的情況下(正常狀況下),可認為是互利共生(一般高中階段認為是這種關係);在致病的情況下,可認為是寄生。
4.培養基中加入伊紅美藍遇大腸桿菌,菌落呈深紫色,並有金屬光澤,可鑑別大腸桿菌是否存在。
5.大腸桿菌在生物技術中的套用:大腸桿菌作為外源基因表達的宿主,遺傳背景清楚,技術操作簡單,培養條件簡單,大規模發酵經濟,倍受遺傳工程專家的重視。目前大腸桿菌是套用最廣泛,最成功的表達體系,常做高效表達的首選體系。
6.大腸桿菌在生態系統中的地位,假如它生活在大腸內,屬於消費者,假如生活在體外則屬於分解者。
7.它的基因組DNA為擬核中的一個環狀分子。同時可以有多個環狀質粒DNA。
8.大腸桿菌細胞的擬核有1個DNA分子,長度約為4 700 000個鹼基對,在DNA分子上分布著大約4 400個基因,每個基因的平均長度約為1 000個鹼基對。
9、大腸桿菌的代謝類型是異養兼性厭氧型。
基因型
大腸桿菌基因型的基本概念
野生大腸桿菌(E.coli)的基因組DNA中有470萬個鹼基對(bp),內含4288個基因。E.coli基因組中還包含有許多插入序列,如λ-噬菌體片段和一些其他特殊組分的片段,這些插入的片段都是由基因的水平轉移和基因重組而形成的,由此表明了基因組具有可塑性。利用大腸桿菌基因組的這種特性對其進行改造,使其中的某些基因發生突變或者缺失,從而給大腸桿菌帶來可以觀察到的變化,這種觀察到的特徵叫做大腸桿菌的表現型(Phenotype),把引起這種變化的基因構成叫做大腸桿菌的基因型(Genotype)。具有不同基因型的菌株表現出不同的特性。這些不同基因型特性的菌株在基因工程的研究和生產中具有廣泛的套用價值。
大腸桿菌的主要基因型
大腸桿菌的主要基因型包括:與基因重組相關的基因型(如recA、recB和recC等)、與甲基化相關的基因型(如dam、dcm、mcrA、mcrB和C、mrr和hsdM等)、與點突變相關的基因型(如mutS、mutT、dut、ung和uvrB等)、與核酸內切酶相關的基因型(如hsdR、hsdS和endA等)、與終止密碼子相關的基因型(如supE和supF)、與抗藥性相關的基因型(gyrA、rpsl和Tn5等)及其他與能量代謝、胺基酸代謝、維生素代謝等相關的基因型。基因工程中,經常使用的大腸桿菌幾乎都來自於K-12菌株,也使用由B株和C株來源的大腸桿菌。
耐酸機制
研究人員在新研究中證實,L-谷氨醯胺通過酶促反應釋放氨,使得大腸桿菌獲得了耐酸性。
 大腸桿菌
大腸桿菌 在三種已知的ARs中,AR1的功能機制仍然不清楚。相比之下,AR2和AR3的分子機製得到了更深入地解析。AR2包含有一個胺基酸反向轉運蛋白GadC,負責細胞外L-谷氨酸(Glu)與細胞內γ-氨基丁酸(γ-aminobutyric acid ,GABA)的交換。兩個Glu脫羧酶GadA和GadB將Glu轉變為GABA。與AR2相似,AR3也具有兩個組件:反向轉運蛋白AdiC和精氨酸脫酸酶AdiA。AR2或AR3一次完整的循環可將細胞質中的質子排出至細胞外環境中,由此提高細胞內pH,促進細菌在酸性環境下存活。
全面了解細菌AR對於有效的臨床預防及治療均有重要的意義。因為所有的食物傳播性致病菌都必須通過極酸性胃,了解細菌在pH值為2-3的環境下的生存機制極其重要。當前,研究人員對於這些機制的了解還遠遠不夠。
在這項研究中,研究人員鑑別了一個新型大腸桿菌耐酸性系統,證實其依賴於谷氨醯胺酶YbaS和胺基酸反向轉運蛋白GadC。這種YbaS和GadC可被酸性pH激活,且只在pH值小於等於6.0時才能適當發揮功能。通過吸收L-谷氨醯胺(Gln),大腸桿菌利用YbaS將之轉化為L-谷氨酸(Glu),伴隨釋放氣態氨。游離氨中和質子,導致酸性環境下細胞內pH增高。GadC則負責細胞外Gln 與細胞內Glu 交換。通過這一耐酸系統,確保了大腸桿菌在極酸性環境下生存。
人體關係
大腸桿菌是與我們日常生活關係非常密切的一類細菌,學名稱作“大腸埃希菌”,屬於腸道桿菌大類中的一種。它是寄生在人體大腸和小腸里對人體無害的一種單細胞生物,結構簡單,繁殖迅速,培養容易,它是生物學上重要的實驗材料。在嬰兒剛出生的幾小時內,大腸桿菌就經過吞咽在腸道內定居了。正常情況下,大多數大腸桿菌是非常安分守己的,他們不但不會給我們的身體健康帶來任何危害,反而還能競爭性抵禦致病菌的進攻,同時還能幫助合成維生素K2,與人體是互利共生的關係。只有在機體免疫力降低、腸道長期缺乏刺激等特殊情況下,這些平日裡的良民才會興風作浪,移居到腸道以外的地方,例如膽囊、尿道、膀胱、闌尾等地,造成相應部位的感染或全身播散性感染。因此,大部分大腸桿菌通常被看作機會致病菌。
分類
根據不同的生物學特性將致病性大腸桿菌分為5類:
致病性大腸桿菌是嬰兒腹瀉的主要病原菌,有高度傳染性,嚴重者可致死;成人少見。
腸產毒性大腸桿菌(ETEC)
引起嬰幼兒和旅遊者腹瀉,出現輕度水瀉,也可呈嚴重的霍亂樣症狀。腹瀉常為自限性,一般2~3天即愈。營養不良者可達數周,也可反覆發作。
腸侵襲性大腸桿菌(EIEC)
腸侵襲性大腸桿菌的特點是能侵入大、小腸黏膜,穿入上皮細胞內,使細胞蛋白溶解並在其中生長繁殖,使黏膜刷狀緣受損,局部發生潰瘍甚至出血,所以臨床大便表現似痢疾。
腸出血性大腸桿菌(E.I"IEC)
患者可能出現各種症狀,包括嚴重的水瀉、帶血腹瀉、發熱、腹絞痛及嘔吐。情況嚴重時,更可能並發急性腎病。5歲以下的兒童出現該等併發症的風險較高。若治療不當,可能會致命。
也可以引起腹瀉,但對其發病機理與血清型尚不了解。EAEC不侵入腸上皮細胞,不產生LT或ST,也無VT毒素。唯一特徵是具有與Hep-2細胞(人喉上皮細胞癌細胞系)粘附的能力,故也稱Hep-2細胞粘附性大腸桿菌。
致病物質
1、定居因子(Colonizationfactor,CF):也稱粘附素(Adhesin),即大腸桿菌的菌毛。致病大腸桿菌須先粘附於宿主腸壁,以免被腸蠕動和腸分泌液清除。使人類致瀉的定居因子為CFAⅠ、CTAⅡ(ColonizationfactorantigenⅠ、Ⅱ),定居因子具有較強的免疫原性,能刺激機體產生特異性抗體。
大腸桿菌具有很多毒力因子,包括內毒素,莢膜,〣型分泌系統,黏附素和外毒素等。(〣型分泌系統是指能向真核靶細胞內輸送毒性基因產物的細菌效應系統。約由20餘種蛋白質組成。)
 大腸桿菌
大腸桿菌 2、黏附素能使細菌緊密黏著在泌尿道和腸道的細胞上,避免因排尿時尿液的沖刷和腸道的蠕動作用而被排除。大腸桿菌黏附素的特點是具有高特異性。包括:定植因子抗原〡,〢,〣;集聚黏附菌毛〡和〣;束形成菌毛;緊密黏附素;P菌毛;侵襲質粒抗原蛋白和Dr菌毛等。
3、外毒素大腸桿菌能產多種的外毒素,包括:志賀毒素〡和〢;耐熱腸毒素〡和〢;不耐熱腸毒素〡和〢。此外,溶血素A在尿路致病性大腸桿菌所致疾病中有重要作用。
4、腸毒素:是腸產毒性大腸桿菌在生長繁殖過程中釋放的外毒素,分為耐 熱和不耐熱兩種。
不耐熱腸毒素(Heatlabileenterotoxin,LT):對熱不穩定,65℃經30分鐘即失活。為蛋白質,分子量大,有免疫原性。由A、B兩個亞單位組成,A又分成A1和A2,其中A1是毒素的活性部分。B亞單位與小腸黏膜上皮細胞膜表面的GM1神經節苷脂受體結合後,A亞單位穿過細胞膜與腺苷酸環化酶作用,使胞內ATP轉化cAMP。當cAMP增加後,導致小腸液體過度分泌,超過腸道的吸收能力而出現腹瀉。LT的免疫原性與霍亂弧菌腸毒素相似,兩者的抗血清交叉中和作用。
耐熱腸毒素(Heatstableenterotoxin,ST):對熱穩定,100℃經20分鐘仍不被破壞,分子量小,免疫原性弱。ST可激活小腸上皮細胞的鳥苷酸環化酶,使胞內cGMP增加,在空腸部分改變液體的運轉,使腸腔積液而引起腹瀉。ST與霍亂毒素無共同的抗原關係。
腸產毒性大腸桿菌的有些菌株只產生一種腸毒素,即LT或ST;有些則兩種均可可產生。有些致病大腸桿菌還可產生vero毒素。
5、其他:脂胞壁多糖的類脂A具有毒性,O特異多糖有抵抗宿主防禦屏障的作用。大腸桿菌的K抗原有吞噬作用。
病原體
 大腸桿菌
大腸桿菌 大腸桿菌O157:H7是大腸桿菌的其中一個類型,該種病菌常見於牛隻等溫血動物的腸內。這一型的大腸桿菌會釋放一種強烈的毒素,並可能導致腸管出現嚴重症狀,如帶血腹瀉。
大腸桿菌血清學分型基礎(即其抗原) 大腸埃希菌主要有三種抗原:O抗原,為細胞壁脂多糖最外層的特異性多糖,由重複的多糖單位所組成。該抗原刺激機體主要產生IgM類抗體(出現早,消失快)。K抗原,位於O抗原外層,為多糖,與細菌的侵襲力有關。K抗原分為A,B,L三型。H抗原,位於鞭毛上,加熱和用酒精處理,可使H抗原變性或喪失。H抗原主要刺激機體產生IgG類抗體,與其他腸道菌基本無交叉反應。
表示大腸桿菌血清型的方式是按O:K:H排列,例如:O111:K58(B4):H2
桿菌危害
認知:
大腸桿菌是原核生物,構造相對簡單,遺傳背景清晰,培養操作容易,因此也常常被作為基因工程的對象加以利用:研究者常常將外源基因導入質粒,將質粒整合入大腸桿菌基因,這樣,大腸桿菌就能夠表達基因重組後的蛋白(例如胰島素,某些疫苗等)了。此外,大腸桿菌還常常作為模型生物參與細胞學實驗。
雖然絕大多數大腸桿菌與人類有著良好合作,但是仍有少部分特殊類型的大腸桿菌具有相當強的毒力,一旦感染,將造成嚴重疫情。其中最具代表性的就是代號為O157:H7的大腸桿菌,它是EHEC(腸出血性大腸桿菌)家族中的一員。提起O157:H7,可謂劣跡斑斑:美國在1982、1984、1993年曾三次發生O157:H7的爆發性流行;日本曾在1996年爆發過一次波及9000多人的大流行。O157:H7感染後的主要症狀正是出血性腹瀉,嚴重者可伴發溶血尿毒綜合徵(HUS),危及生命。由於O157:H7危害較大,且可經食物和飲用水在人群中廣泛傳播,因此食品衛生主管部門已將O157:H7列為常規檢測項目。此次在德國肆虐的O104也是一種EHEC,感染症狀類似O157:H7,且毒力更為猛烈。
症狀:
人體感染EHEC後,會發生嚴重的痙攣性腹痛和反覆發作的出血性腹瀉,同時伴有發熱、嘔吐等表現,多為EHEC產生的毒素所致。某些嚴重感染者毒素隨血行播散造成溶血性貧血,紅細胞、血小板減少;腎臟受到波及時還會發生急性腎功能衰竭甚至死亡。通常情況下大腸桿菌對多種抗生素敏感,但耐藥的菌株也不少見。此次爆發於德國的O104由於可產生分解抗生素的酶,故治療更為棘手——一旦採取抗生素治療,反倒會引起細菌產生更多的志賀樣毒素(SLT),加重病情。因此對於我們普通人而言,對付此類病菌感染的最佳手段還是預防:不吃不熟的肉類食品如生魚,生牛肉(O157因對牛低毒而很容易被牛攜帶,因此食用未熟的牛肉易導致O157感染)等,食用生鮮瓜果前要徹底清洗,遇有腹瀉儘早上醫院。
潛伏期
通常為3至4日,但亦會長達9日。
導致疾病
1、腸道外感染
 大腸桿菌顯色培養基
大腸桿菌顯色培養基 多為內源性感染,以泌尿系感染為主,如尿道炎、膀胱炎、腎盂腎炎。也
可引起腹膜炎、膽囊炎、闌尾炎等。嬰兒、年老體弱、慢性消耗性疾病、大面積燒傷患者,大腸桿菌可侵入血流,引起敗血症。早產兒,尤其是生後30天內的新生兒,易患大腸桿菌性腦膜炎。
2、急性腹瀉
某些血清型大腸桿菌能引起人類腹瀉。其中腸產毒性大腸桿菌會引起嬰幼兒和旅遊者腹瀉,出現輕度水瀉,也可呈嚴重的霍亂樣症狀。腹瀉常為自限性,一般2~3天即愈,營養不良者可達數周,也可反覆發作。腸致病性大腸桿菌是嬰兒腹瀉的主要病原菌,有高度傳染性,嚴重者可致死。細菌侵入腸道後,主要在十二指腸、空腸和迴腸上段大量繁殖。此外,腸出血性大腸桿菌會引起散發性或暴發性出血性結腸炎,可產生志賀氏毒素樣細胞毒素。
根據其致病機理不同,分為以下幾種類型。
腸產毒性大腸桿菌(EnterotoxigenicE.coli,ETEC):引起嬰幼兒和旅遊者腹瀉,出現輕度水瀉,也可呈嚴重的霍亂樣症狀。腹瀉常為自限性,一般2~3天即愈。營養不良者可達數周,也可反覆發作。致病因素是LT或ST,或兩者同時致病。有些菌株具有定居因子,常見者為O6:K15:H16、O25:K7:H42。鑑定ETEC主要測定大腸桿菌腸毒素,血清型有一定參考意義。
腸致病性大腸桿菌(EnteropathogenicE.coli,EPEC):是嬰兒腹瀉的主要病原菌,有高度傳染性,嚴重者可致死;成人少見。細菌侵入腸道後,主要在十二指腸、空腸和迴腸上段大量繁殖。切片標本中可見細菌粘附於絨毛,導致刷狀緣破壞、絨毛萎縮、上皮細胞排列紊亂和功能受損,造成嚴重腹瀉。EPEC不產生LT或ST。有人報導,EPEC可產生一種由噬菌體編碼的腸毒素,因對Vero細胞(綠猴腎傳代細胞)有毒性,故稱VT毒素。VT毒素的結構、作用與志賀氏毒素相似,具有神經毒素、細胞毒素和腸毒素性。鑑定EPEC可根據臨床表現與血清型。
EIEC的多數菌株無動力,生化反應和抗原結構均近似痢疾桿菌,應予注意。EIEC可引起豚鼠角結合膜炎,臨床上可藉此協助鑑定EIEC。
舉例
病原體:大腸桿菌O157 : H7是大腸桿菌的其中一個類型,該種病菌常見於牛隻等溫血動物的腸內。這一型的大腸桿菌會釋放一種強烈的毒素,並可能導致腸管出現嚴重症狀,如帶血腹瀉。
病徵:患者可能出現各種症狀,包括嚴重的水瀉、帶血腹瀉、發燒、腹絞痛及嘔吐。情況嚴重時,更可能並發急性腎病。5歲以下的兒童出現該等併發症的風險較高。若治療不當,可能會致命。
傳播途徑
腸出血性大腸桿菌感染是一種人畜共患病。凡是體內有腸出血性大腸桿菌感染的病人、帶菌者和家畜、家禽等都可傳播本病。動物作為傳染源的作用尤其重要,較常見的可傳播本病的動物有牛、雞、羊、狗、豬等,也有從鵝、馬、鹿、白鴿的糞便中分離出O157H7大腸桿菌的報導。其中以牛的帶菌率最高,可達16%,而且牛一旦感染這種細菌,排菌時間至少為一年。
可通過飲用受污染的水或進食未熟透的食物(特別是免治牛肉、漢堡扒及烤牛肉)而感染。飲用或進食未經消毒的奶類、芝士、蔬菜、果汁及乳酪而染病的個案亦有發現。此外,若個人衛生欠佳,亦可能會通過人傳人的途徑,或經進食受糞便污染的食物而感染該種病菌。
患病或帶菌動物往往是動物來源食品污染的根源。如牛肉、奶製品的污染大多來自帶菌牛。帶菌雞所產的雞蛋、雞肉製品也可造成傳播。帶菌動物在其活動範圍內也可通過排泄的糞便污染當地的食物、草場、水源或其他水體及場所,造成交叉污染和感染,危害極大。
1. 通過食物傳播
O157H7大腸桿菌主要是通過污染食物而引起人的感染,O157H7大腸桿菌的致病能力和對胃酸的抵抗力均較強,對細胞的破壞性大。因此很多國家將O157H7大腸桿菌引起的感染性腹瀉歸為食源性疾病。在世界各地報告的爆發中,約有70%以上與進食可疑食物有關。
動物來源的食物,如牛肉、雞肉、牛奶、奶製品等是O157H7大腸桿菌經食物傳播的主要因素,尤其是在動物屠宰過程中這些食物更易受到寄生在動物腸道中的細菌污染。另外蔬菜、水果等被O157H7大腸桿菌污染也可造成大腸桿菌感染爆發。
1982年和1993年在美國發生的O157H7大腸桿菌感染性腹瀉的爆發,就是由於食用了某快餐連鎖店的漢堡包引起的。研究證明,漢堡包的牛肉餡被O157H7大腸桿菌污染。據專家估計100個菌就可使人發病,而1個漢堡包的牛肉餡里可含有1000個細菌,足以使人得病。
英國曾發生一起與食用蔬菜有關的O157H7感染爆發。
1996年5-8月份在日本發生的世界上最大的一起由O157H7大腸桿菌引起的爆發流行,可疑食物是牛肉和工業化生產的蔬菜。
1991、1993、1996年在美國發生的O157H7感染爆發被證明了食用被污染的蘋果汁和蘋果酒。
1998年,中國黑龍江省衛生防疫站首次從市售的熟豬頭肉中分離出EHEC,表明中國也存在由該菌引起食物中毒的危險。
2. 通過水傳播
1989年,在美國密蘇里州發生的一起O157H7大腸桿菌感染爆發,共發病240多人。調查表明,該起爆發可能為水源性,是由於飲用水被污染所致。加強飲用水源的消毒管理後,疫情得到了控制。
1989年12月-1990年1月在加拿大某鎮也發生了一起O157H7大腸桿菌感染爆發。在2000多名居民中,發病243人,發病率11.6%。經證實也為水源性爆發。原因為天氣寒冷,供水管道堵塞,導致市政供水系統受污染。
除了飲用水受到污染可造成感染外,其他被污染的水體如游泳池、湖水及其他地表水等都可造成傳播。這也進一步說明了O157H7在外環境中的生存能力較強,引起人類感染可能並不需要在外環境中進行增菌。
1991年在美國的俄勒岡州發生的一起O157H7大腸桿菌感染爆發,懷疑是湖水被糞便污染,感染者在湖水裡游泳時不慎喝了湖水而被感染。
對1992年在蘇格蘭發生的一起O157H7大腸桿菌感染的調查發現,一個患病兒童在一個家庭用的大水盆里玩耍,污染了盆里的水,結果用過同一盆水的兒童都先後發病。
1996年在日本大坂發生O157H7大腸桿菌感染爆發後,鑒於O157H7大腸桿菌可經水傳播,有關當局關閉了大坂市的23個公共游泳池和515所學校的游泳池。
3.密切接觸傳播
人與人之間的密切接觸也可引起O157H7大腸桿菌的傳播。
一個人感染了O157H7大腸桿菌後,常通過密切接觸的方式把細菌傳染給其父母、子女、兄弟姐妹或其他與之密切接觸的人如老師、朋友、親戚等。
在醫院裡,也發生了多起由於護士照料病人而感染了O157H7大腸桿菌的報告,並且得到了病原學上的支持。
值得指出的是:在人與人之間的傳播過程中,二代病人症狀往往較輕,很少出現出血性腸炎。可能是由於接觸傳播時感染劑量小或經人傳代後細菌毒力減弱。
在上述三條傳播途徑中,以食物傳播為主。有人對美國自1982年起發生的100多起 O157H7爆發流行的感染途徑進行統計,發現食源性的占71%(52%為牛肉製品,大部分與快餐店中的漢堡包有關;14%為水果、蔬菜;5%來源於未知食品)、16%為人與人接觸感染、12%為水源性感染。
防治方法
預防方法
1.保持地方及廚房器皿清潔,並把垃圾妥為棄置。
2.保持雙手清潔,經常修剪指甲。
大腸桿菌平板培養基
大腸桿菌平板培養基 3、進食或處理食物前,套用肥皂及清水洗淨雙手,如廁或更換尿片後亦應洗手。
4.食水應採用自來水,並最好煮沸後才飲用。
5.應從可靠的地方購買新鮮食物,不要光顧無牌小販。不要吃不乾淨的東西
6.避免進食高危食物,例如未經低溫消毒法處理的牛奶,以及未熟透的漢堡扒、碎牛肉和其它肉類食品。
7.烹調食物時,應穿清潔、可洗滌的圍裙,並戴上帽子。
8.食物應徹底清洗。
9.易腐壞食物套用蓋蓋好,存放於雪櫃中。
10.生的食物及熟食,尤其是牛肉及牛的內臟,應分開處理和存放(雪柜上層存放熟食,下層存放生的食物),避免交叉污染。
11.雪櫃應定期清潔和融雪,溫度應保持於攝氏4度或以下。
12.若食物的所有部分均加熱至攝氏75度,便可消滅大腸桿菌O157 : H7;因此,碎牛肉及漢堡扒應徹底煮至攝氏75度達2至3分鐘,直至煮熟的肉完全轉為褐色,而肉汁亦變得清澈。
13.不要徒手處理熟食;如有需要,應戴上手套。
14.食物煮熟後應儘快食用。
15.如有需要保留吃剩的熟食,應該加以冷藏,並儘快食用。食用前應徹底翻熱。變質的食物應該棄掉。
16. 體質弱、衰老、出差、旅遊等應激狀態下,可以補食乳酸菌,預防大腸桿菌的發病。
治療方法
感染大腸桿菌O157 :H7的臨床治理方法主要屬支持性治療。若患者出現腹瀉,補充失去的水分及電解質十分重要。約50%有腎併發症的患者在出現急性症狀時需要特別治療或輸血。可使用抗革蘭氏陰性菌細菌藥物,但部分藥物無效
研究進展
2014年5月,研究人員發現,大腸桿菌和耐甲氧西林金黃色葡萄球菌等致病菌能夠在機艙中生存數日。在飛機上,人們時常觸摸的表面——例如扶手、塑膠摺疊餐桌和遮光簾—— 十分危險,這裡的病菌最為繁盛。耐甲氧西林金黃色葡萄球菌能在椅背後的口袋布上生存1周,大腸桿菌在扶手上能待4天。相關研究結果發表於美國微生物學協會 會議。
套用影響
在生物技術中的套用
大腸桿菌作為外源基因表達的宿主,遺傳背景清楚,技術操作簡單,培養條件簡單,大規模發酵經濟,倍受遺傳工程專家的重視。目前大腸桿菌是套用最廣泛,最成功的表達體系,常做高效表達的首選體系
在這裡必須指出的是,處於生物安全考慮,生物工程用的菌株是在不斷篩選後被挑選出的菌株。這些菌株由於失去的細胞壁的重要組分,所以在自然條件下已無法生長。甚至普通的清潔劑都可以輕易地殺滅這類菌株。這樣,即便由於操作不慎導致活菌從實驗室流出,也不易導致生化危機。此外,生物工程用的菌株基因組都被最佳化過,使之帶有不同基因型(例如β半乳糖甘酶缺陷型),可以更好的用於分子克隆實驗
真核基因在大腸桿菌中表達,必須有合適的表達載體(Vector),常用載體:pBV220,pET系統
目的基因在大腸桿菌中表達的情況:
 大腸桿菌
大腸桿菌 大腸桿菌更適合原核基因的表達,外源基因表達產量與單位體積產量是正相相關的,而單位體積產量與細胞濃度和每個細胞平均表達產量呈正相相關.細胞濃度與生長速率,外源基因拷貝數和表達 產物產量之間存在動態平衡,單個細胞的產量又與外源基因拷貝數,基因表達效率,表達產物的穩定性和細胞代謝負荷等因素有關。
例如,科學家們把人的胰島素基因送到大腸桿菌的細胞里,讓胰島素基因和大腸桿菌的遺傳物質相結合。人的胰島素基因在大腸桿菌的細胞里指揮著大腸桿菌生產出了人的胰島素。並隨著它的繁殖,胰島素基因也一代代的傳了下去,後代的大腸桿菌也能生產胰島素了。這種帶上了人工給予的新的遺傳性狀的細菌,被稱為基因工程菌。
對養殖業的影響
當前大腸桿菌病給養禽業帶來的損失越來越大,其難於治癒、死亡率高、極易復發等臨床特點,正困擾著基層廣大養殖戶和獸醫工作者。那么大腸桿菌病為何如此難於根治呢?通常多考慮的是抗菌素耐藥、繼發或並發感染、藥物靶部位等因素,其實還忽視了一個引起包心包肝、氣囊炎、敗血症、腸炎及發熱等常見臨床病症的另一個重要元兇——大腸桿菌死亡溶解釋放的內毒素。
內毒素是由革蘭氏陰性菌(大腸桿菌、沙門氏菌、鴨疫里默氏桿菌等)細胞壁的成份,是一種脂多糖。內毒素對機體有很強的毒性,可引起宿主發熱、毒血症、敗血症、心包炎、肝周炎、氣囊炎、輸卵管炎、腎炎,甚至休剋死亡。由於內毒素只有菌體死亡溶解後才能被釋放,因此在治療革蘭氏陰性菌感染的疾病時,如果單純大量套用抗菌素,會使細菌死亡並釋放更多的內毒素,使上述症狀得不到緩解,甚至出現內毒素性休克,而使死亡增加。因此當前控制細菌病尤其是大腸桿菌病,不但要抑殺細菌,更要清除內毒素。“治炎素”的抗菌機制正與大腸桿菌的上述致病機理相吻合。
基因工程
優點
遺傳背景清楚、載體受體系統完備、生長迅速、培養簡單、重組子穩定
缺點
產結構複雜、種類繁多的內毒素
用途
是基因工程主要原核受體菌。外源DNA克隆和擴增;原核基因高效表達;基因文庫構建。
檢查方法
細菌的分離鑑定
1、標本:腸道外感染取中段尿、血液、膿液、腦脊液等,腹瀉者取糞便。
2、分離培養與鑑定:糞便標本直接接種腸道桿菌選擇性培養基。血液需先經肉湯增菌,再轉種血瓊脂平板。其他標本可同時接種血瓊脂平板和腸道桿菌選擇性培養基。37℃孵育18~24小時後,觀察菌落並塗片染色鏡檢。採用一系列生化反應進行鑑定。腸致病性大腸桿菌須先作血清學定型試驗。必要時檢定腸黴毒素。
泌尿系統除確定大腸桿菌外,還應計數,每毫升尿含菌量≥100,000時,才有診斷價值。
衛生細菌學檢查
大腸桿菌不斷隨糞便排出體外,污染周圍環境和水源、食品等。取樣檢查時,樣品中大腸桿菌越多,表示樣品被糞便污染越嚴重,也表明樣品中存在腸道致病菌的可能性越大。故應對飲水、食品、飲料進行衛生細菌學檢查。
1、細菌總數:檢測每毫升或每克樣品中所含細菌數,採用傾注培養計算。中國規定的衛生標準是每毫升飲水中細菌總數不得超過100個。
2、大腸菌數指數:指每立升中大腸菌群數,採用乳糖發酵法檢測。中國的衛生標準是每1000ml飲水中不得超過3個大腸菌群;瓶裝汽水、果汁等每100ml大腸菌群不得超過5個。
全自動微生物定量分析儀(TEMPO)檢測
全自動微生物定量分析(TEMPO)儀的大腸桿菌群計數檢測有TC和CC兩種方法。TEMPO TC的開發是為了獲得NF ISO4832標準相當性能水平。TEMPO CC法是TEMPO儀器上根據BAM方法專門用於24h計數食品中大腸桿菌群的方法。該法是為了獲得和AOAC官方方法966.24及美國公共健康聯合會檢測乳製品檢測方發(SMEDP)一致的效果。TEMPO系統根據陽性空的大小和數目來推算出原始樣本中大腸桿菌群數目。
食品檢測方法
大腸菌群MPN 計數法
1 樣品的稀釋
1.1 固體和半固體樣品:稱取25 g 樣品,放入盛有225 mL 磷酸鹽緩衝液或生理鹽水的無菌均質杯內,
8000 r/min~10000 r/min 均質1 min~2 min,或放入盛有225 mL 磷酸鹽緩衝液或生理鹽水的無菌均質袋
中,用拍擊式均質器拍打1 min~2 min,製成1:10 的樣品勻液。
1.2 液體樣品:以無菌吸管吸取25 mL 樣品置盛有225 mL 磷酸鹽緩衝液或生理鹽水的無菌錐形瓶
(瓶內預置適當數量的無菌玻璃珠)中,充分混勻,製成1:10 的樣品勻液。
1.3 樣品勻液的pH 值應在6.5~7.5 之間,必要時分別用1 mol/L NaOH 或1 mol/L HCl 調節。
1.4 用1 mL 無菌吸管或微量移液器吸取1:10 樣品勻液1 mL,沿管壁緩緩注入9 mL 磷酸鹽緩衝液
或生理鹽水的無菌試管中(注意吸管或吸頭尖端不要觸及稀釋液面),振搖試管或換用1 支1 mL 無菌
吸管反覆吹打,使其混合均勻,製成1:100 的樣品勻液。
1.5 根據對樣品污染狀況的估計,按上述操作,依次製成十倍遞增系列稀釋樣品勻液。每遞增稀釋
1 次,換用1 支1 mL 無菌吸管或吸頭。從製備樣品勻液至樣品接種完畢,全過程不得超過15 min。
2.初發酵試驗
每個樣品,選擇3個適宜的連續稀釋度的樣品勻液(液體樣品可以選擇原液),每個稀釋度接種3
管月桂基硫酸鹽胰蛋白腖(LST)肉湯,每管接種1mL(如接種量超過1 mL,則用雙料LST肉湯),36
℃±1 ℃培養24 h±2 h,觀察倒管內是否有氣泡產生,24 h±2 h產氣者進行復發酵試驗,如未產氣則繼續
培養至48 h±2 h,產氣者進行復發酵試驗。未產氣者為大腸菌群陰性。
3.復發酵試驗
用接種環從產氣的LST肉湯管中分別取培養物1環,移種於煌綠乳糖膽鹽肉湯(BGLB)管中,36 ℃±1
℃培養48 h±2 h,觀察產氣情況。產氣者,計為大腸菌群陽性管。
4.大腸菌群最可能數(MPN)的報告
按3確證的大腸菌群LST陽性管數,檢索MPN表(見附錄B),報告每g(mL)樣品中大腸菌群的
MPN值。
大腸菌群平板計數法
1 樣品的稀釋
按上一方法稀釋。
2 平板計數
2.1 選取2個~3個適宜的連續稀釋度, 每個稀釋度接種2個無菌平皿,每皿1 mL。同時取1 mL生理鹽
水加入無菌平皿作空白對照。
2.2 及時將15 mL~20 mL冷至46 ℃的結晶紫中性紅膽鹽瓊脂(VRBA)約傾注於每個平皿中。小心
鏇轉平皿,將培養基與樣液充分混勻,待瓊脂凝固後,再加3 mL~4 mLVRBA復蓋平板表層。翻轉平
板,置於36 ℃±1 ℃培養18 h~24 h。
3 平板菌落數的選擇
選取菌落數在15 CFU~150 CFU 之間的平板,分別計數平板上出現的典型和可疑大腸菌群菌落。
典型菌落為紫紅色,菌落周圍有紅色的膽鹽沉澱環,菌落直徑為0.5 mm 或更大。
4 證實試驗
從VRBA 平板上挑取10 個不同類型的典型和可疑菌落,分別移種於BGLB 肉湯管內,36 ℃±1 ℃
培養24 h~48 h,觀察產氣情況。凡BGLB 肉湯管產氣,即可報告為大腸菌群陽性。
相關研究
大腸桿菌是現代生物學中研究最多的一種細菌,作為一種模式生物,其基因組序列已全部測出。用分子生物學方法在大腸桿菌得出的結論可用於其它生物的研究。此外,在生物工程中,大腸桿菌被廣泛用於基因複製和表達的宿主。
2013年9月30日,韓國研究人員全球首次研發出製取汽油的大腸桿菌。就像酵母分解糖分製作啤酒的原理一樣,該微生物可將雜草或木渣轉化成汽油。
相關疫情
疫情暴發
人體在食用這種毒黃瓜後,很容易因感染而出現腹部絞痛和腹瀉等症狀。同時,有的患者還會出現危及生命的溶血性尿毒綜合徵,其臨床表現是急性腎衰竭、溶血性貧血和血小板減少。
,截止到2011年06月03日腸出血性大腸桿菌(EHEC)已造成
。患者主要分布在德國北部,其中漢堡和石荷州最為嚴重,共出現400多例確診或疑似病例。德國負責流行病預防研究的權威機構羅伯特·科赫研究所2011年5月26日上午報告說,德國腸出血性大腸桿菌病例從未如此集中暴發,德國一周來出現的病例相當於過去一年的總和,患者中三分之二是女性,除德國之外,英國、法國、荷蘭、丹麥、瑞典等國,都不同程度地出現了類似病例
。
德國漢堡衛生研究所26日宣布在產自西班牙的黃瓜上檢測出了EHEC病菌,蔬菜色拉,尤其是源自德國北部的上述食品。
德國農業部門2011年6月5日表示,該國自產的“豆芽”可能是造成22人死亡,2200人住院治療的大腸桿菌疫情爆發罪魁。據悉,德國北部下薩克森州農業部確定,該州農場生產的豆芽引發了本次疫情,並要求人們停止食用帶有生豆芽的沙拉冷盤
。
揭開原因
 德國公布致命大腸桿菌顯微鏡下照片
德國公布致命大腸桿菌顯微鏡下照片 柏林2011年6月10日電(記者劉向)德國國家疾病控制中心羅伯特·科赫研究所等多家機構10日在柏林表示,他們已確認豆芽等芽苗菜是造成此次腸出血性大腸桿菌(EHEC)疫情的源頭。當局同時宣布,生吃黃瓜、西紅柿和生菜是安全的。羅伯特·科赫研究所所長布格爾當天在德國疾病控制、衛生檢疫等多個部門聯合舉行的新聞發布會上說,這一結果基於100多名在某餐廳就餐的顧客的跟蹤調查。他們發現,這些顧客中感染腸出血性大腸桿菌的患者都吃了帶有生芽苗菜的食物,食用芽苗菜者患病的幾率是未食用者的9倍。越來越多的證據顯示,下薩克森州比嫩比爾特的一家農場生產的芽苗菜是這次疫情傳染源頭。這家農場已經完全查封。有關機構表示,正在檢查其他生產芽苗菜的農場。但迄今,調查人員還沒有從任何食物樣本中找到病原體——腸出血性大腸桿菌O104:H4,包括在這家農場以及飯館、患者家的廚房獲取的樣本。
源頭探究
德國下薩克森州官員2011年6月5日宣布,初步調查顯示由該州一家企業向不少本次德國腸出血性大腸桿菌疫情較重的地區供應的豆芽等芽苗菜很可能是造成疫情的一個傳染源,該州衛生防疫部門甚至建議民眾勿食用豆芽。而昨日,下薩克森州農業部又宣布,對被疑是腸病疫情傳染源的芽苗菜的初步抽樣檢查並沒有發現腸出血性大腸桿菌。
歐洲疾控中心5日稱,此次疫情死亡人數已增至22人,感染個案升至2263宗。
一度召回豆芽
德國下薩克森州農業部長林德曼5日下午舉行記者招待會說,位於該州于爾岑縣的一家企業曾向漢堡、石荷州、梅前州、黑森州和下薩克森州等疫情較重的地區供應過用來做涼拌色拉的綠豆芽等多種芽苗菜。這家企業的一名女職工已被確診感染腸出血性大腸桿菌,另一名職工也出現腹瀉症狀。種種跡象顯示,這家企業至少可能是本次疫情的一個重要傳染源。
林德曼說,這家企業共加工了18種芽苗菜,其種子來自德國其他地區、其他歐洲國家和亞洲國家。病菌既可能來源於種子,也可能源於用於培養芽苗的約37攝氏度的溫水。在這家企業查到的18種芽苗菜包括綠豆芽、鷹嘴豆芽、蘿蔔芽、小紅蘿蔔芽和綠菜花芽。
這家農場已被關閉,已發出的貨物正被召回。該農場經理日前則對媒體表示,對他產品的指責毫無意義,發芽所需的材料僅是種子和溫水,根本沒有用肥料,而且該農場根本不使用任何動物糞便作為肥料。據悉,大腸桿菌通常都存在於動物腸道中,因此動物糞便也被認為是可能的傳播途徑。
可能跟沼氣有關
不過,德國衛生部長丹尼爾·巴爾及RKI研究所所長雷納德·布爾格暫時對疫情的最新發現表態謹慎。布爾格強調,該所專家和聯邦各州正通過多個線索查找病菌的傳播途徑,線索非常多,涉及多家餐館及各種食物。而衛生部長巴爾則認為,在明確結果尚未知曉前,不應妄加猜測。
一周前,衛生防疫部門認為產自西班牙的黃瓜是致病源,但隨後又推翻了這一論斷。儘管在西班牙黃瓜上檢出了埃希大腸桿菌,但其菌株與此次疫情的菌株並不一致。
較早前曾有德國科學家懷疑,大腸桿菌有可能來自生物氣體(即沼氣)生產廠,甚至不排除有人蓄意污染食物來發動恐怖攻擊。由於提倡使用生物能源,德國現有6800座沼氣生產廠,通過分解及發酵糞便污水生產沼氣。奧古斯堡的醫學實驗室創辦人紹特多爾夫說,沼氣發酵容器中不同細菌交集,出現前所未有的新型細菌,而這些帶有新型病菌的東西近80%最後被當做肥料。
法國疫情初現
法國衛生官員2013年6月24日說,疑似在法國引發腸出血性大腸桿菌疫情的植物種子由英國企業提供。
其中6人2013年6月8日在貝格勒鎮孤兒院一場聚會上吃過帶大腸桿菌的芽苗菜發生便血。截至24日晚,10名患者中7人繼續接受治療,其中5人的腎臟出現併發症。
法國經濟部分管消費事務的國務秘書弗雷德里克·勒菲弗說,法國種植用品連鎖店雅爾迪蘭德售出的植物種子培育成芽苗菜後,供應食客,而這些種子來自英國種子和植物郵購企業湯普森—摩根,可能是疫情“源頭”。
湯普森-摩根公司辯解說,該公司從許多地方大批買進芽苗菜種子再進行分銷,與本次疫情有關的種子可能是來自義大利。法國疫情的原因也可能是當地在培育芽苗菜時出了問題,與種子本身無關。
英國食品標準署25日發布公告說,法國出現的一些大腸桿菌病例被懷疑與英國湯普森-摩根公司出售的芽苗菜種子有關,雖然英國本土還沒有發現相關病例,但出於安全考慮提醒公眾,在食用苜蓿、豆類和葫蘆巴的種子以及由它們培育的芽苗菜時,需要煮熟到從裡到外冒熱氣的程度,不能生吃。
疫情影響
這輪大腸桿菌疫情暴發之初,德國衛生部門曾懷疑產自西班牙的黃瓜是疫情源頭。歐洲多國隨即發布對西班牙蔬菜和水果的進口禁令,招致西班牙方面的強烈抗議。德國政府隨後承認判斷有誤。
自歐洲多國出現腸道疾病疫情一周以來,由於傳染源不明,法國蔬菜行業受到嚴重打擊。據法國蔬菜行業協會3日初步估計,受疫情影響,法國僅黃瓜和西紅柿種植者的損失就高達480萬歐元(約合702萬美元)。
顯微鏡下的致命病菌病毒
盤點與我們一同生活的微生物
| 每個人都覺得自己是孤獨的,但全部知道有無數的細菌陪在我們的身邊,讓我們來好好認識一下它們吧! |

